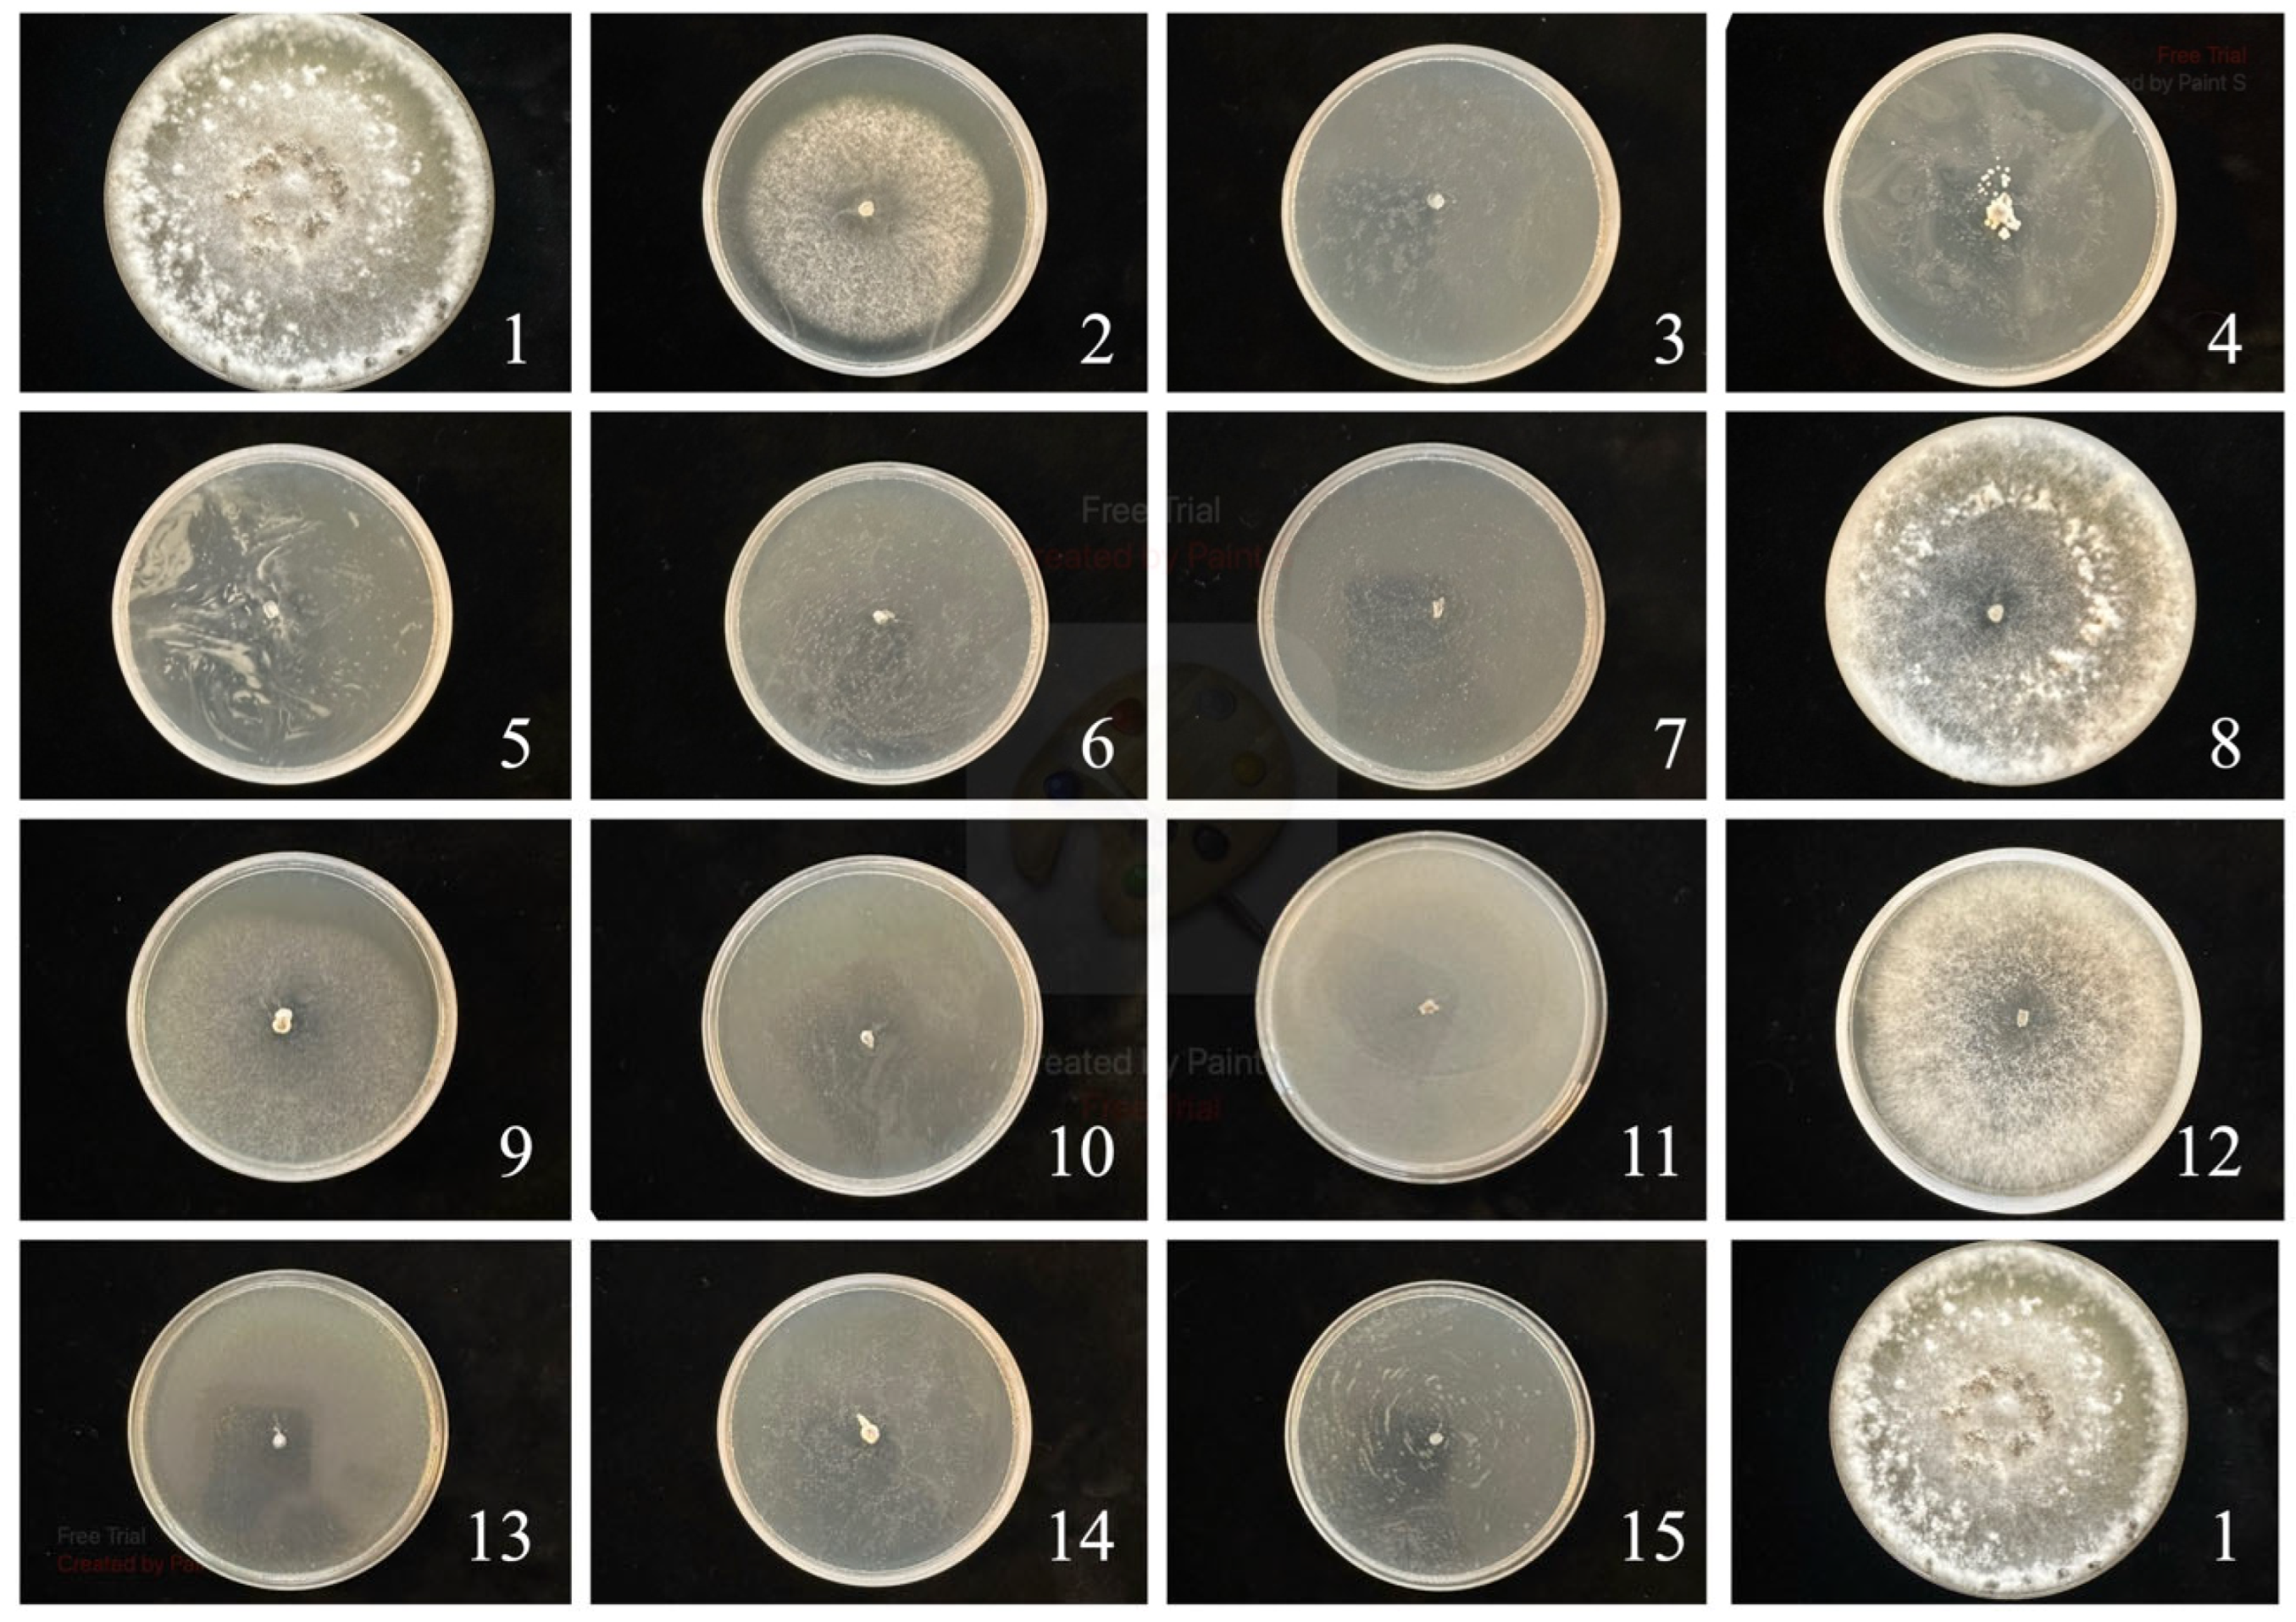
Agriculture 15 02214 g001

Abstract
The increasing demand for sustainable agricultural practices has led researchers to explore alternative methods for controlling plant diseases and pests. Among these alternatives, essential oils (EOs) derived from various plant species have gained significant attention due to their broad-spectrum antimicrobial properties, which can be utilized in plant protection. Essential oils are volatile compounds that possess strong aromatic characteristics and are found in many medicinal and aromatic plants. They are known for their antifungal, antibacterial, and insecticidal activities, making them viable candidates for eco-friendly pest and disease management strategies. In this research, six essential oils—pine, patchouli, geranium, spruce, coriander, and eucalyptus oil—have been tested in vitro for controlling mycelium growth of Sclerotinia sclerotiorum, Botrytis cinerea, Alternaria brassicicola, and Cylindrosporium concentricum. The study also covers experiments in controlling pollen beetle and cabbage seed weevil (laboratory trials). In greenhouse conditions, the phytotoxicity of EOs to oilseed rape (Brassica napus L.) and the effect of these substances on the control of cornflower (Centaurea cyanus) were also tested. The results obtained indicate a large diversity of different essential oils in terms of their action on pathogens, pests, weeds, and winter rapeseed. Differences in their effectiveness were also found, depending on the applied dose.
1. Introduction
Oilseed rape (Brassica napus L.) cultivation faces significant challenges from various diseases and pests that affect yield and crop quality worldwide. Among the most important fungal diseases is gray mold, caused by Botrytis cinerea, which infects leaves, stems, and pods, leading to considerable yield losses under humid conditions [1]. Another critical disease is Sclerotinia stem rot, incited by Sclerotinia sclerotiorum, notorious for its extensive host range and ability to survive in soil through sclerotia, making control difficult [1,2]. A. brassicicola leads to Alternaria leaf spot or black spot disease, characterized by necrotic lesions on leaves and pods, contributing to seed quality deterioration [3]. Another important oilseed rape disease is Cylindrosporiosis, caused by Cylindrosporium concentricum. The pathogen mainly attacks the leaves, forming light brown to grayish circular or irregular necrotic spots surrounded by a dark border. Although the disease has been reported sporadically in Europe [4,5], recent climatic fluctuations and the expansion of oilseed rape cultivation have increased its occurrence in some regions. One of the important weed species affecting oilseed rape cultivation is cornflower (Centaurea cyanus L.) This annual broadleaf weed typically germinates in autumn and survives the winter [6,7,8]. Its current distribution varies by region—occurring less frequently in Western Europe [8,9,10] but remaining relatively common in Central Europe [7,11,12,13,14]. Both the pollen beetle (Brassicogethes aeneus F.) and the cabbage seed weevil (Ceutorhynchus obstrictus M.), which were selected for our experiments, are among the key pests of this crop in Poland and other European countries, often requiring multiple chemical treatments with synthetic plant protection products [15].
The increasing demand for sustainable agricultural practices has led researchers to explore alternative methods for controlling plant diseases, weeds, and pests. Among these alternatives, essential oils (EOs) derived from various plant species have gained significant attention due to their broad-spectrum antimicrobial properties, which can be utilized in plant protection. Essential oils are volatile compounds that possess strong aromatic characteristics and are found in many medicinal and aromatic plants. They are known for their antifungal, antibacterial, and insecticidal activities, making them viable candidates for eco-friendly pest and disease management strategies [16,17]. The application of essential oils not only offers a potential control measure for plant diseases but also aligns with the growing consumer preference for organic and environmentally friendly agricultural practices. The integration of EOs into pest management programs can help reduce reliance on synthetic pesticides, mitigate the risk of resistance development in pathogens (agrophages), and enhance the sustainability of agricultural systems [18,19].
Essential oils exhibit antifungal, antibacterial, and antiviral properties, making them promising candidates for managing plant diseases. For instance, studies have demonstrated that essential oils can inhibit the growth of various phytopathogenic fungi, including Fusarium and Botrytis species, which are notorious for causing significant crop losses [20,21]. The essential oil of Lippia sidoides has been shown to effectively inhibit the mycelial growth of Bipolaris maydis, a pathogen responsible for leaf spot diseases in maize [22]. This efficacy is attributed to the complex mixture of terpenes and other bioactive compounds present in essential oils, which can disrupt fungal cell walls and interfere with their metabolic processes [23].
Essential oils demonstrate strong antifungal properties through several interconnected mechanisms that target fundamental structural and metabolic elements of fungal cells. Due to their chemically diverse composition, EOs can compromise fungal cell membranes by modifying their fluidity and permeability. Such alterations cause leakage of intracellular materials and eventual cell death, often through interactions with ergosterol, an essential sterol component of fungal membranes [24,25]. EOs also impede spore germination, a critical step in fungal propagation, by damaging membrane integrity and stimulating the production of reactive oxygen species (ROS) [25,26]. EOs inhibit enzymes essential for fungal development and cell wall formation. Additionally, EOs have been shown to disrupt the function of glucan synthase, cytochrome c oxidase, NADH dehydrogenase, catalase, superoxide dismutase, and phospholipases, collectively impairing cell wall integrity, mitochondrial respiration, energy metabolism, and antioxidant defense mechanisms [27,28,29,30,31,32]. Overall, the diverse antifungal modes of action of plant essential oils underscore their value as natural biofungicides capable of disrupting multiple cellular targets, simultaneously offering promising, environmentally sustainable alternatives to conventional synthetic fungicides [33,34].
The insecticidal properties of essential oils are also well-documented. They can act as neurotoxins, affecting the nervous systems of various pests.
Essential oils derived from aromatic plants are considered promising bioinsecticidal agents due to their multiple mechanisms of action and low environmental impact. Oils such as pine, patchouli, geranium, spruce, coriander, and eucalyptus contain mono- and sesquiterpenes that affect insects mainly through modulation of neuronal ion channels, inhibition of acetylcholinesterase, and induction of oxidative stress. In addition, their volatile compounds interfere with insect olfactory receptors, resulting in repellence, orientation disruption, and feeding deterrence. Pine and spruce oils rich in α- and β-pinene act rapidly but transiently, while patchouli oil, dominated by patchoulol, provides long-lasting repellency. Geranium and coriander oils exhibit strong olfactory and neurotoxic effects, and eucalyptus oil containing 1,8-cineole shows both repellent and larvicidal activity. Eucalyptus oil has demonstrated significant toxicity against common agricultural pests, including aphids and beetles [16,35]. These oils can be used in integrated pest management (IPM) strategies, offering a sustainable alternative to conventional pesticides. They are particularly valued for their rapid degradation and low environmental impact, which help maintain ecological balance [36]. Collectively, these essential oils represent valuable natural components for integrated pest management strategies with minimal risk to pollinators [37,38].
In addition to controlling diseases and pests, essential oils have shown potential in weed management. Certain essential oils can inhibit seed germination and seedling growth of various weed species, thereby reducing competition for resources with crops. For instance, clove oil has been effective as a bioherbicide, causing damage to both broadleaf and grass weeds [39].
The effects of essential oils on weeds can be multifaceted. They consist of mixtures of many substances, which means they can exhibit several mechanisms of action. Therefore, the risk of resistance to EO is low [40]. They can induce excessive generation of reactive oxygen species, leading to oxidative stress and ultimately tissue damage [41]. The application of essential oils can negatively impact the pigment content and photosynthesis in plants [42]. Among the effects of essential oils on plants, additional effects include waxy cuticular layer removal, decreased cellular respiration, ion leakage and membrane depolarization, mitosis inhibition, and microtubule polymerization [43]. The search for new mechanisms of herbicide action is important in the context of the growing problem of weed resistance [44]. One weed species with an increasing number of resistant biotypes is cornflower [45]. This weed occurs in crops such as winter rapeseed and cereals (HRAC) [46].
These properties highlight the versatility of essential oils in promoting crop health by managing unwanted plant species. In this research, six essential oils have been tested for controlling the mycelium growth of the most common fungi isolated from oilseed rape plant tissues, in addition to selected pests and weeds prominent in oilseed rape cultivation.
The aim of the study was to assess the potential use of selected essential oils in the control of the most important plant pathogens and pests of oilseed rape: Sclerotinia sclerotiorum, Botrytis cinerea, Alternaria brassicicola, Cylindrosporium concentricum, Brassicogethes aeneus F., and Ceutorhynchus obstrictus M. The study also aimed to evaluate the phytotoxicity of the tested substances to oilseed rape (Brassica napus L.) and their herbicidal efficacy against Centaurea cyanus L.
2. Materials and Methods
The following essential oils were used in the experiment: pine (Pinus sylvestris), patchouli (Pogostemon cablin), geranium (Pelargonium graveolens), spruce (Picea excelsa), coriander (Coriandrum sativum), and eucalyptus (Eucalyptus citriodora), which came from a commercial source (Etja, Elbląg, Poland). The compositions of essential oils were assessed on a gas chromatograph according to the methodology of Grzanka et al. [47] The results include the five substances that occurred in the largest amounts. The composition of essential oils depended on the plant from which the compounds came (Table 1). The composition of geranium essential oil was dominated by citronellol, and the second most important ingredient was geraniol. In the case of spruce essential oil, the dominant substances were α-Pinene and myrcene. Beta-Linalool and geranyl acetate were the main components of coriander essential oil, while eucalyptol and p-Cymene dominated in the composition of eucalyptus essential oil. The composition of patchouli essential oil was dominated by patchoulol, and the second most important ingredient was δ-Guaiene. In the case of pine essential oil, the dominant substances were α-pinene and β-pinene.

Table 1.
Main ingredients of the tested essential oils (% in volume v/v).
2.1. Disease Control (Mycelium Growth In Vitro)
The experiment was carried out in June 2025. Fragments of infected stems showing disease symptoms were surface-disinfected and transferred onto potato dextrose agar (PDA) medium. Emerging fungal colonies derived from plant tissue fragments were subcultured and further incubated. Fungal isolates were identified based on colony morphology and the characteristics of macroconidia, following standard mycological identification keys. All isolates are maintained in the culture collection of the Laboratory of Mycology, Department of the Institute of Plant Protection—National Research Institute (IPP-NRI, Poznań, Poland).
The tested compounds were incorporated into sterilized PDA medium cooled to 45 °C, in amounts providing the desired active substance concentrations. A synthetic fungicide, prothioconazole, served as a reference compound. Each tested agent was evaluated at two concentrations, as specified in Table 2. The resulting mixtures were poured into Petri dishes (90 mm dimension). The experiment was carried out in five replicates, while the control treatment consisted of PDA medium without any additives.

Table 2.
Mean values, Fisher’s least significant differences (LSDs), and F-statistics from analysis of variance for mycelium growth of four fungi.
Isolates of Sclerotinia sclerotiorum, Botrytis cinerea, Alternaria brassicicola, and Cylindrosporium concentricum were obtained. Those isolates demonstrating the highest pathogenicity were selected for greenhouse pathogenicity assessments and subsequently used in this experiment. Agar discs (4 mm in diameter) from the actively growing margins of each fungal culture were placed in the center of solidified PDA plates. The plates were incubated under controlled conditions at 20 °C in a Binder growth chamber (Sanyo ElectricIncubator MIR-254, PHC Europe BV, Etten-Leur, The Netherlands), with a temperature regime of 20 °C for 14 h during the light period and 14 °C for 10 h at night.
The colony diameter was measured once the mycelium completely covered the control plates (for each of the examined fungi) or, for slow-growing species, after three weeks of incubation. Mean mycelial growth (in millimeters) was then calculated. All assays were conducted in two independent experimental series, and the mean values from both series were combined and presented in the final table.
2.2. Weed Control
The study involved winter oilseed rape (Brassica napus L.) and cornflower (Centaurea cyanus). Seeds were sown in Kronen peat substrate. When the plants reached the 2–3 leaf stage, treatments were applied using a greenhouse sprayer equipped with TeeJet 1102 nozzles (TeeJet Technologies GmbH, Schorndorf, Germany). The spray volume was 200 L ha−1, and the working pressure was maintained at 0.2 MPa. Control plants were left untreated.
The effectiveness and potential phytotoxicity of each substance were visually evaluated 1 and 10 days after application (DAA). Results were expressed as a percentage scale from 0% to 100%, where 0% indicated no visible effect and 100% represented complete plant destruction.
Chlorophyll fluorescence measurements were performed 1 DAA using a modulated fluorometer (OS5p, Opti-Sciences, Inc., Hudson, NY, USA) to determine the Fv/Fm—the maximum quantum efficiency of PSII photochemistry. Measurements were conducted on the youngest leaves after 30 min of dark adaptation using white darkening clips. Instrument parameters were adjusted to maintain a stable fluorescence signal between 150 and 250 units. Two readings were taken for each replicate.
2.3. Insect Control
Essential oils were combined with ethoxylated rapeseed oil (Rokacet RZ17, PCC Group, Brzeg Dolny, Poland) in a 4:1 ratio. Each formulation was applied at four different doses (2, 5, and 10 L ha−1). The experiment included three replicates for each treatment combination.
Pollen beetle (Brassicogethes aeneus F.) and cabbage seed weevil (Ceutorhynchus obstrictus M.) populations were collected from fields that had not been treated with insecticides before (three locations: Winna Góra, Rogalin, and Rokietnica). The beetles were transferred to the laboratory, kept in the refrigerator (4 °C) for one night, and used for tests on the following day.
The IRAC method, relying on the exposure of the tested insects to their host plants’ material (oilseed inflorescences and leaves) treated with different concentrations of the tested products, was used for the tests. Treatments relied on dipping the plant material in water solutions of the tested products for 5 s and drying them after that. A specialized emulsifier (Solubol 1%) for essential oils was used to dissolve the tested oils. Dry plant material was placed in glass containers (1 l jars), together with living insects (100 pollen beetles, 50 cabbage seed weevils). Each version included three repetitions. The glass containers were kept at 20 °C and under a photoperiod of 12 h/12 h for 24 h. The mortality of insects was assessed after 24 h. Still or severely paralyzed insects were recognized as dead.
Tested products:
- Essential oils: 1% and 2% (solution).
- Lambda-cyhalothrin (Karate Zeon 050 CS containing 4.81% active ingredient): applied field dose—0.125 kg ha−1 (30 ppm a.i.) (ppm concentration was calculated, assuming the usage of 200 L of water per hectare).
2.4. Statistical Analysis
To confirm the assumption that the distribution of results in the analyzed data groups is a normal distribution, the Shapiro–Wilk W-test was implemented. The Brown–Forsythe test was implemented to evaluate the homogeneity of variances. Visual assessment of phytotoxicity of applied mixtures and photosynthetic parameters (Fo and Fv/Fm) data were analyzed as a two-way analysis of variance (ANOVA) using the Statistica 13 software (StatSoft Polska Sp. z o.o., Krakow, Poland). Tukey’s test (HSD) was employed to determine homogeneous groups if the influence of a factor on a characteristic was conclusively demonstrated at a significance level of p = 0.05.
A multivariate analysis of variance (MANOVA) was carried out to determine the effects of essential oils for mycelium growth of four fungi; one-way analyses of variance (ANOVA) were carried out to determine the effects of essential oils on the variability of mycelium growth of these four fungi independently. Mean values of mycelium growth for each of the four fungi were calculated. The distribution of observed traits was graphically presented in density plots. Fisher’s least significant differences (LSDs) were estimated at a significance level of α = 0.05. Homogeneous groups for the analyzed traits were determined based on LSDs. The relationships between the observed traits were estimated using Pearson correlation coefficients and presented graphically as a heatmap. The results were also analyzed using multivariate methods. A canonical variate analysis was applied in order to present a multi-trait assessment of the similarity of the tested essential oils in a lower number of dimensions with the least possible loss of information [48]. This facilitated graphic presentation of any variation in the essential oils in terms of all the observed traits. The Mahalanobis distance was suggested as a measure of similarity for “polytrait” essential oils [49], the significance of which was verified by means of the critical value Dα, “the least significant distance” [50]. Mahalanobis distances were calculated for all pairs of the essential oils. All the analyses were conducted using the GenStat 23 statistical software package (VSN International, Hemel Hemstead, UK).
3. Results
3.1. Disease Control
The effects of the individual essential oils on inhibiting the growth of the studied fungi varied depending on the type and dose of the oil used (Table 2). The addition of geranium and coriander oils to PDA medium, at both tested doses, resulted in complete inhibition of Sclerotinia sclerotiorum mycelial growth (Figure 1). Patchouli oil also strongly inhibited mycelial growth—14.47 mm at a dose of 5.0 mL and 6.33 mm at 10.0 mL—as did pine oil (3.33 mm) applied at 10.0 mL. Statistically significant inhibition of fungal growth compared to the control was also observed for pine oil (46.33 mm) and eucalyptus oil (53.33 mm), both at a dose of 5.0 mL, as well as for spruce oil (58.33 mm) applied at 10.0 mL. The addition of prothioconazole to the medium completely inhibited growth at the higher dose. At the lower dose of 1.75 L ha−1, the mycelial diameter was 3.0 mm.

Figure 1.
S. sclerotiorum control. The numbers correspond to the numbers in Table 2.
Similarly, in the case of S. sclerotiorum, geranium oil at both doses completely inhibited mycelial growth. Coriander oil also exhibited this effect at both tested doses. Other tested oils—except eucalyptus and spruce oils at 5.0 mL—reduced the growth of Botrytis cinerea. In these combinations, the mycelial diameter ranged from 5.00 to 45.67 mm. The application of prothioconazole significantly inhibited B. cinerea growth, with mycelial diameters of 24.33 mm at the lower dose and 7 mm at the higher dose.
The essential oils used to inhibit the growth of Alternaria brassicicola also showed inhibitory effects compared to the control, except for eucalyptus oil at 5.0 mL. The strongest inhibition of mycelial growth was observed for geranium oil at both tested doses (complete inhibition at 10.0 mL) and coriander oil at 10.0 mL. Prothioconazole, applied at both doses, also significantly inhibited A. brassicicola growth, with mycelial diameters of 9.67 mm and 5.67 mm, respectively.
The growth of Cylindrosporium concentricum mycelium was inhibited by all essential oils tested, except for eucalyptus oil at 5.0 mL. Geranium and coriander oils completely inhibited mycelial growth at both doses. The addition of a triazole fungicide to the PDA medium also limited the fungal growth (18.67 mm and 11.67 mm, respectively).
The results of ANOVA indicated that the main effects of the essential oils were significant for all the four observed fungi (Table 2). The range of inhibition efficacy across fungal species is presented in Figure 2.

Figure 2.
Range of inhibition efficacy (min–max) across fungal species.
The greatest variation in terms of all the four fungi jointly measured with Mahalanobis distances was found for control and Geranium EO 2 (the distance between them amounted to 25.88). The greatest similarity was found between Geranium EO 1 and Coriander EO. For these two oils, identical values were observed for the growth of all four fungi (Table 3, Figure 3).

Table 3.
Mahalanobis distance between all pairs of tested substances.

Figure 3.
Distribution of tested substances in the space of the first two canonical variables (V1 and V2).
3.2. Weed Control
One day after applying the essential oils, minor damage was observed on cornflowers after applying geranium essential oil and patchouli EO (Table 4). However, no signs of damage were observed during an assessment performed 10 days after application. Geranium essential oil and patchouli EO contributed most to the damage to winter oilseed rape, which was observed mostly in assessment 1 DAA (Table 4). In the combinations where essential oils were applied, however, the young leaves showed no signs of damage. During measurements of the maximum photochemical efficiency of photosystem II performed on cornflower one day after the application of oils, no statistically significant decreases in the value of this parameter were found (Table 4).

Table 4.
The effect of essential oils on cornflower and oilseed rape damage (%).
Geranium essential oil and patchouli EO contributed to the greatest decrease in the maximum photochemical efficiency of photosystem II of winter rapeseed when measured 1 day after application of the oils, but all values were higher than 0.75 (Table 5).

Table 5.
Effect of essential oils on the maximum photochemical efficiency of photosystem II (non-nominated units).
Application of geranium EO caused the most damage to winter rapeseed (Figure 4). However, the symptoms were transient.

Figure 4.
Geranium EO highest dose.
3.3. Insect Control
The mortality of pollen beetles (Brassicogethes aeneus F.) (Table 6) varied significantly depending on the type of essential oil and its concentration. The highest average mortality was recorded for geranium oil (87.5%) and coriander oil (87.5%), with the 2% solution of coriander oil achieving complete (100%) mortality. Moderate efficacy was observed for patchouli oil (38.3%), eucalyptus oil (32.5%), and spruce oil (20.8%). In contrast, pine oil exhibited very low insecticidal activity (2.5%). Overall, the 2% concentration resulted in higher mortality (53.3%) than the 1% concentration (36.4%), although the magnitude of this effect varied among oils (Figure 5a).

Table 6.
Mortality [%] of Brassicogethes aeneus after application of 1% and 2% solutions of selected essential oils (means ± standard deviation).

Figure 5.
Density plot of mortality of (a) Brassicogethes aeneus F. obstrictus F.; (b) Ceutorhynchus.
The mortality of cabbage seed weevils (Ceutorhynchus obstrictus) (Table 7) differed significantly depending on the type of essential oil, concentration, and their interaction. The highest mean mortality was recorded for coriander oil (88.33%) and geranium oil (85.83%), with 2% solutions of both oils achieving 100% mortality. Moderate efficacy was observed for patchouli (42.50%), eucalyptus (31.67%), and spruce (18.33%) oils, while pine oil showed minimal activity (3.33%). Overall, the 2% concentration resulted in higher mortality (54.72%) than the 1% concentration (35.28%) (Figure 5b).

Table 7.
Mortality [%] of Ceutorhynchus obstrictus after application of 1% and 2% solutions of selected essential oils (means ± standard deviation).
4. Discussion
The cultivation of oilseed rape (Brassica napus) is significantly impacted by various pests, pathogens, and weeds, which pose challenges to achieving optimal yields and maintaining crop quality. The increasing pressure to reduce chemical pesticide usage due to environmental concerns has led to a renewed interest in exploring natural alternatives, such as essential oils, for pest and disease management [51].
Essential oils are composed of highly complex mixtures of volatile compounds, usually comprising 20–60 constituents, though in some cases the number may exceed 400, as observed in jasmine, lemon, and cinnamon oils. Recent studies indicate that essential oils are increasingly applied in pest management, targeting fungi (plant pathogens), bacteria, and insects [52,53,54,55].
The antifungal properties of essential oils such as thyme (Thymus vulgaris) and oregano (Origanum vulgare) have been documented against various phytopathogens, including those affecting oilseed rape [56]. For instance, the essential oil of thyme has been reported to inhibit the growth of pathogens like Alternaria spp. and Fusarium spp., which are known to cause significant yield losses in oilseed rape cultivation [57]. The ability of these essential oils to induce systemic resistance in plants adds an additional layer of protection against fungal infections, promoting healthier crop development [58]. Similar laboratory experience with limiting the growth of mycelium, using S. sclerotiorum among others, on the medium BDA by applying various essential oils were led by Fontana et al. [59] The authors indicated the effective concentration for 50% control of mycelial growth of S. Sclerotiorum and a dose that completely inhibited the growth of mycelium. Differences were shown for individual oils: 0.8 for Aloysia citridor, 1.0 for Cymbopogon winterianus 1.0, 0.4 for Lippia alba, and −1.4 for Ocimum americanum (µL·mL−1).
Other laboratory studies [57] measured the impact of oils on the increase in selected allergic fungi, such as Botrytis cinerea and Alternaria alternata, which can also appear in rapeseed. Of the surveyed oils, only the use of oregano oil at all concentrations (0.1, 0.25, and 0.5) completely limited the increase in mycelium of the tested fungi.
Studies [60] on limiting the growth of Botrytis cinerea after the use of various plant extracts showed more than 60% reduction in colony size compared to the control in a dose-dependent manner. The best results in limiting B. cinerea were achieved after adding essential oils from bee balm plants to the medium. EOs from bee balm plants contained 36 compounds.
In the present study, the highest efficacy in suppressing the mycelial growth of S. sclerotiorum, B. cinerea, A. brassicicola, and C. concentricum was achieved with the application of geranium and coriander essential oils. These findings are of particular significance, considering the well-recognized challenges associated with managing the development of these pathogens by natural compounds. By comparison, [61] reported inhibitory effects of patchouli and spruce essential oils on S. sclerotiorum; however, the isolates assessed in that study were obtained from leguminous crops.
Among the evaluated essential oils, the application of pine EO at an increased dose showed a high efficacy in reducing the mycelial growth of the tested pathogenic fungi. A similar trend was noted when eucalyptus oil was applied at a higher dose. Moreover, both doses of geranium oil and both doses of coriander oil resulted in growth inhibition levels of the examined fungi that were comparable to those achieved with the synthetic fungicide containing prothioconazole at the higher dose. These findings highlight the potential of certain essential oils to provide fungicidal effects similar to those of conventional chemical treatments.
These observations may serve as a valuable complement to the results reported by [62,63], who demonstrated the fungistatic properties of geranium oil against yeast species of the genus Candida. Taken together, these findings broaden the current understanding of the antifungal potential of geranium oil, indicating that its inhibitory effects are not limited to yeast-like fungi but may also extend to important plant pathogenic species.
The results obtained for eucalyptus oil are consistent with the observations of other authors [64] who demonstrated its antifungal efficacy against pathogenic species including Penicillium funiculosum, Aspergillus niger, and Aspergillus flavus. In the present study, eucalyptus essential oil most effectively inhibited the mycelial growth of Sclerotinia sclerotiorum and Botrytis cinerea, particularly at the higher tested dose.
No significant herbicidal efficacy was observed for the oils used against cornflower. Some of them caused damage to rapeseed plants, but the damage was transient. This may be due to the contact effect of the essential oils, which results in healthy young leaves after application of appropriate doses. This raises the possibility of using them against other pests while maintaining the safety of crop plants. Fv/Fm indicates the maximum quantum efficiency of photosystem II [65]. The value of this parameter in healthy plants is in the range of approximately 0.78–0.84 [66,67]. Under conditions of plant stress, a decrease in the value of this parameter is observed, which indicates dissipation of excitation energy in the form of heat [68,69].
In terms of pest control, essential oils have demonstrated efficacy against major insect pests of oilseed rape, such as aphids and flea beetles. The use of neem oil (Azadirachta indica) has been particularly notable for its insecticidal properties, disrupting the growth and reproduction of pests while being relatively safe for beneficial organisms [1]. The integration of essential oils into pest management protocols not only aids in reducing pest populations but also minimizes the risk of developing pest resistance, a significant concern associated with conventional insecticides.
In the scientific literature, there are few publications addressing the control of the pollen beetle (Brassicogethes aeneus F.) and the cabbage seed weevil (Ceutorhynchus obstrictus M.) using plant oils. Pavela [70] conducted such studies and demonstrated the insecticidal activity of caraway (Carum carvi) oil against the pollen beetle. Beetles exposed for six hours to a surface sprayed with this oil, at a concentration of 197 µg/cm2, showed mortality at the LD50 level. In the case of thyme oil (Thymus vulgaris), the LD50 after six hours was reached at a concentration of 250 µg/cm2. For other oils, such as dill, cinnamon, citrus, lavender, peppermint, catnip, and basil oils, LD50 was reached at concentrations up to 1508 µg/cm2. S. Slug et al. [71] reported 88.8% mortality of the cabbage seed weevil using cinnamon (Cinnamomum verum) and cumin (Cuminum cyminum) oils. At the same time, in these authors’ studies, the mentioned oils also caused mortality in non-target organisms, leading to the conclusion that further research is necessary to assess the effects of selected essential oils on the honeybee and other beneficial insect species.
The multifaceted benefits of essential oils extend beyond pest and disease control. They can enhance the overall resilience of oilseed rape against biotic stressors by priming the plant’s defense mechanisms. This aligns with the principles of integrated pest management, which advocate for the use of biological control agents in conjunction with other agricultural practices.
Despite the potential advantages, the commercial uptake of essential oils in agriculture faces challenges, such as high volatility, variability in chemical composition, and the need for effective application methods. Research indicates that encapsulating essential oils in nanoparticles or formulating them into stable emulsions could enhance their efficacy and stability, thereby broadening their application in crop protection.
5. Conclusions
The use of essential oils presents a viable alternative for managing diseases, pests, and weeds in oilseed rape cultivation. Their integration into existing agricultural practices could support sustainable crop production while reducing the environmental impact associated with chemical pesticides. The laboratory findings confirm the considerable potential of essential oils in OSR cultivation; however, further investigations are required under greenhouse and field conditions to validate and extend these results.
Author Contributions
Conceptualization, J.D. and J.H.; methodology, J.D., J.H., M.K. and E.J.; software, J.B.; validation, J.D., J.H., P.W., D.D., J.Z., E.J., M.G., Ł.S., J.B., K.S.-S. and M.B.; formal analysis, J.D., J.H., P.W., D.D., M.K., J.Z., E.J., M.G., Ł.S. and K.S.-S.; investigation, J.D., J.H., P.W., D.D., J.Z., E.J., M.G., Ł.S. and K.S.-S.; resources, J.D., J.H., M.G. and E.J.; data curation, J.D., J.H., P.W., D.D., J.Z., E.J., M.G., R.I., Ł.S., M.B. and K.S.-S.; writing—original draft preparation, J.D., J.H., P.W., D.D., J.Z., E.J., M.G., Ł.S. and K.S.-S.; writing—review and editing, J.D., J.H., P.W., D.D., J.Z., E.J., M.G., Ł.S., R.I. and K.S.-S.; visualization, J.D., J.H., P.W., D.D., J.Z., E.J., M.G., Ł.S., M.B. and K.S.-S.; supervision, J.D. and J.H.; project administration, J.D. and J.H.; funding acquisition, J.D. and J.H. All authors have read and agreed to the published version of the manuscript.
Funding
This research was supported by the Institute of Plant Protection—National Research Institute.
Institutional Review Board Statement
Not applicable.
Data Availability Statement
The data presented in this study, including raw measurement results, statistical analyses, and microscopic or photographic documentation, were collected in June 2025 and are available on reasonable request from the corresponding author. The data are not publicly available due to institutional and project-related restrictions.
Conflicts of Interest
The authors declare no conflicts of interest.
References
- Zamani-Noor, N. Baseline Sensitivity and Control Efficacy of Various Group of Fungicides against Sclerotinia sclerotiorum in Oilseed Rape Cultivation. Agronomy 2021, 11, 1758. [Google Scholar] [CrossRef]
- Zamani-Noor, N.; Brand, S. Overview of the joint research project “SkleroPro”-Evaluation of environmental factors affecting Sclerotinia sclerotiorum. In Working Group Integrated Control in Oilseed Crops, Proceedings of the Online Meeting; IOBC-WPRS: Braunschweig, Germany, 17–18 May 2022; Volume 157, pp. 36–39. [Google Scholar]
- Kumar, D.; Maurya, N.; Bharati, Y.K.; Kumar, A.; Kumar, K.; Srivastava, K.; Chand, G.; Kushwaha, C.; Singh, S.K.; Mishra, R.K.; et al. Alternaria blight of oilseed Brassicas: A comprehensive review. Afr. J. Microbiol. Res. 2014, 8, 2816–2829. [Google Scholar] [CrossRef]
- Boys, E.F.; Roques, S.E.; Ashby, A.M.; Evans, N.; Latunde-Dada, A.O.; Thomas, J.E.; West, J.S.; Fitt, B.D.L. Resistance to infection by stealth: Brassica napus (winter oilseed rape) and Pyrenopeziza brassicae (light leaf spot). Eur. J. Plant Pathol. 2007, 118, 307–321. [Google Scholar] [CrossRef]
- Karolewski, Z.; Evans, N.; Fitt, B.D.L.; Todd, A.D.; Baierl, A. Sporulation of Pyrenopeziza brassicae (light leaf spot) on oilseed rape leaves inoculated with ascospores or conidia at different temperatures and wetness durations. Plant Pathol. 2002, 51, 654–665. [Google Scholar] [CrossRef]
- Stankiewicz-Kosyl, M.; Synowiec, A.; Haliniarz, M.; Wenda-Piesik, A.; Domaradzki, K.; Parylak, D.; Wrochna, M.; Pytlarz, E.; Gala-Czekaj, D.; Marczewska-Kolasa, K.; et al. Herbicide Resistance and Management Options of Papaver rhoeas L. and Centaurea cyanus L. Agronomy 2020, 10, 874. [Google Scholar] [CrossRef]
- Jursik, M.; Holec, J.; Andr, J. Biology and control of another important weeds of the Czech Republic: Cornflower (Centaurea cyanus L.). Listy Cukrov. Reparske 2009, 125, 90–93. [Google Scholar]
- Petit, C.; Arnal, H.; Darmency, H. Effect of fragmentation and population size on the genetic diversity of Centaurea cyanus L. (Asteraceae) population. Plant. Ecol. Evolut. 2015, 148, 191–198. [Google Scholar] [CrossRef]
- Sutcliffe, O.L.; Kay, Q.O.N. Changes in the arable flora of central southern England since the 1960s. Biol. Conserv. 2000, 93, 1–8. [Google Scholar] [CrossRef]
- Baessler, C.; Klotz, S. Effects of changes in agricultural land-use on landscape structure and arable weed vegetation over the last 50 years. Agric. Ecosyst. Environ. 2006, 115, 43–50. [Google Scholar] [CrossRef]
- Kolárová, M.; Tyšer, L.; Soukup, J. Impact of site conditions and farming practices on the occurrence of rare and endangered weeds on arable land in the Czech Republic. Weed Res. 2013, 53, 489–498. [Google Scholar] [CrossRef]
- Dąbkowska, T.; Grabowska-Orządała, M.; Łabza, T. The study of the transformation of segetal flora richness and diversity in selected habitats of southern Poland over a 20-year interval. Acta Agrobot. 2017, 70, 1712. [Google Scholar] [CrossRef]
- Hofmeijer, M.A.; Gerowitt, B. The regional weed vegetation in organic spring-sown cereals is shaped by local management, crop diversity and site. Jul. Kühn Arch. 2018, 458, 288–294. [Google Scholar]
- Staniak, M.; Haliniarz, M.; Kwiecińska-Poppe, E.; Harasim, E.; Wesołowski, M. Diversity of agrocoenoses in the Lublin region, Poland. Acta Agrobot. 2017, 70, 1722. [Google Scholar] [CrossRef]
- Zamojska, J.; Węgorek, P.; Olejarski, P.; Mrówczyński, M. Differentiation of susceptibility levels of oilseed rape pests to the same active substances of insecticides on the example of pollen beetle and cabbage seed weevil. Prog. Plant Prot. 2014, 54, 163–166. [Google Scholar] [CrossRef]
- Isman, M.B. Plant essential oils for pest and disease management. Crop Prot. 2000, 19, 603–608. [Google Scholar] [CrossRef]
- Alkan, M. Essential Oils of Origanum Species from Turkey: Repellent Activity Against Stored Product Insect Pests. J. Agric. Sci. 2023, 29, 103–110. [Google Scholar] [CrossRef]
- Isman, M.B. Commercial opportunities for pesticides based on plant essential oils in agriculture, industry, and consumer products. Phytochem. Rev. 2010, 10, 197–204. [Google Scholar] [CrossRef]
- Ooka, Y.; Nacar, S.; Putievsky, E.; Ravid, U.; Yaniv, Z.; Spiegel, Y. Nematicidal activity of essential oils and their components against the root-knot nematode. Phytopathology 2000, 90, 710–715. [Google Scholar] [CrossRef]
- Okorska, S.B.; Dąbrowska, J.A.; Głowacka, K.; Pszczółkowska, A.; Jankowski, K.J.; Jastrzębski, J.P.; Oszako, T.; Okorski, A. The Fungicidal Effect of Essential Oils of Fennel and Hops against Fusarium Disease of Pea. Appl. Sci. 2023, 13, 6282. [Google Scholar] [CrossRef]
- Sivakumar, D.; Bautista-Baños, S. A review on the use of essential oils for postharvest decay control and maintenance of fruit quality during storage. Crop Prot. 2014, 64, 27–37. [Google Scholar] [CrossRef]
- Mourão, D.D.S.C.; Souza, M.R.D.; Dos Reis, J.V.L.; Ferreira, T.P.D.S.; Osorio, P.R.A.; Santos, E.R.D.; Da Silva, D.B.; Tschoeke, P.H.; Campos, F.S.; Dos Santos, G.R. Fungistatic activity of essential oils for the control of bipolaris leaf spot in maize. J. Med. Plants Res. 2019, 13, 280–287. [Google Scholar] [CrossRef]
- Bakkali, F.; Averbeck, S.; Averbeck, D.; Idaomar, M. Biological effects of essential oils: A review. Food Chem. Toxicol. 2008, 46, 446–475. [Google Scholar] [CrossRef]
- Cenobio-Galindo, A.d.J.; Hernández-Fuentes, A.D.; González-Lemus, U.; Zaldívar-Ortega, A.K.; González-Montiel, L.; Madariaga-Navarrete, A.; Hernández-Soto, I. Biofungicides based on plant extracts: On the road to organic farming. Int. J. Mol. Sci. 2024, 25, 6879. [Google Scholar] [CrossRef]
- Zhao, Z.; Yu, M.; Wei, Y.; Xu, F.; Jiang, S.; Chen, Y.; Ding, P.; Shao, X. Cinnamon Essential Oil Causes Cell Membrane Rupture and Oxidative Damage of Rhizopus Stolonifer to Control Soft Rot of Peaches. Food Control 2025, 170, 111039. [Google Scholar] [CrossRef]
- Attia, M.; Mohamad, A.; Baiumy, M.; Saleh, A.; Reyad, N.E.-H. Antifungal activity of thyme and clove essential oil nanoemulsions against pothos root rot. Egypt. J. Agric. Sci. 2024, 75, 78–92. [Google Scholar] [CrossRef]
- Liao, H.; Wen, J.; Nie, H.; Ling, C.; Zhang, L.; Xu, F.; Dong, X. Study on the inhibitory activity and mechanism of Mentha haplocalyx essential oil nanoemulsion against Fusarium oxysporum growth. Sci. Rep. 2024, 14, 16064. [Google Scholar] [CrossRef] [PubMed]
- Hou, T.; Sana, S.S.; Li, H.; Xing, Y.; Nanda, A.; Netala, V.R.; Zhang, Z. Essential oils and its antibacterial, antifungal, and antioxidant activity applications: A review. Food Biosci. 2022, 47, 101716. [Google Scholar] [CrossRef]
- Yang, Y.; Sun, Q.; Zhang, Y.; Huang, J.; Ma, W.; Yang, Q.; Tong, Z.; Zhang, J. Antifungal activity and mechanism of Phoebe bournei wood essential oil against two dermatophytes. Front. Microbiol. 2025, 16, 1539918. [Google Scholar] [CrossRef]
- Shahina, Z.; Al Homsi, R.; Price, J.D.; Whiteway, M.; Sultana, T.; Dahms, T.E. Rosemary essential oil and its components 1, 8-cineole and α-pinene induce ROS-dependent lethality and ROS-independent virulence inhibition in Candida albicans. PLoS ONE 2022, 17, e0277097. [Google Scholar] [CrossRef] [PubMed]
- Zhao, Y.; Wang, Q.; Wu, X.; Jiang, M.; Jin, H.; Tao, K.; Hou, T. Unraveling the polypharmacology of a natural antifungal product, eugenol, against Rhizoctonia solani. Pest. Manag. Sci. 2021, 77, 3469–3483. [Google Scholar] [CrossRef]
- Liao, M.; Yang, Q.Q.; Xiao, J.J.; Huang, Y.; Zhou, L.J.; Hua, R.M.; Cao, H.Q. Toxicity of Melaleuca alternifolia essential oil to the mitochondrion and NAD+/NADH dehydrogenase in Tribolium confusum. Peer J. 2018, 6, e5693. [Google Scholar] [CrossRef]
- Fonseca-Guerra, I.R.; Posada, A.M.V.; Rozo, M.E.B.; Pineda, M.E.B. Essential oils of thyme (Thymus vulgaris) and oregano (Origanum vulgare) as an alternative for the control of pesticide-resistant Fusarium spp. in quinoa seeds. J. Sci. Food Agric. 2025, 15, 2236–2245. [Google Scholar] [CrossRef]
- Siddiqui, T.; Khan, M.U.; Sharma, V.; Gupta, K. Terpenoids in Essential Oils: Chemistry, classification, and potential 621 impact on human health and industry. Phytomed. Plus 2024, 4, 100549. [Google Scholar] [CrossRef]
- Koul, O.; Singh, R.; Kaur, B.; Kanda, D. Comparative study on the behavioral response and acute toxicity of some essential oil compounds and their binary mixtures to larvae of Helicoverpa armigera, Spodoptera litura and Chilo partellus. Ind. Crops Prod. 2008, 49, 428–436. [Google Scholar] [CrossRef]
- Mwamburi, L.A. Role of Plant Essential Oils in Pest Management. In New and Future Development in Biopesticide Research: Biotechnological Exploration; Mandal, S.D., Ramkumar, G., Karthi, S., Jin, F., Eds.; Springer: Singapore, 2022; pp. 157–185. [Google Scholar]
- Regnault-Roger, C.; Vincent, C.; Arnason, J.T. Essential oils in insect control: Low-risk products in a high-stakes world. Annu. Rev. Entomol. 2012, 57, 405–424. [Google Scholar] [CrossRef]
- Pavela, R. Essential oils for the development of eco-friendly mosquito larvicides: A review. Ind. Crops Prod. 2015, 76, 174–187. [Google Scholar] [CrossRef]
- Božik, M.; Nový, P.; Klouček, P. Chemical composition and antimicrobial activity of cinnamon, thyme, oregano and clove essential oils against plant pathogenic bacteria. Acta Univ. Agric. Silvic. Mendel. Brun. 2017, 65, 1129–1134. [Google Scholar] [CrossRef]
- Pavela, R.; Benelli, G. Essential oils as ecofriendly biopesticides? Challenges and constraints. Trends Plant. Sci. 2016, 21, 1000–1007. [Google Scholar] [CrossRef] [PubMed]
- Ni, X.Z.; Bai, H.D.; Han, J.C.; Zhou, Y.; Bai, Z.D.; Luo, S.Q.; Xu, J.; Jin, C.; Li, Z. Inhibitory activities of essential oils from Syzygium aromaticum inhibition of Echinochloa crusgalli. PLoS ONE 2024, 16, e0304863. [Google Scholar] [CrossRef]
- Kaur, S.; Singh, H.P.; Batish, D.R.; Kohli, R.K. Chemical characterization and allelopathic potential of volatile oil of Eucalyptus tereticornis against Amaranthus viridis. J. Plant Interact. 2011, 6, 297–302. [Google Scholar] [CrossRef]
- Raveau, R.; Fontaine, J.; Lounès-Hadj Sahraoui, A. Essential oils as potential alternative biocontrol products against plant pathogens and weeds: A review. Foods 2020, 9, 365. [Google Scholar] [CrossRef] [PubMed]
- He, B.; Hu, Y.; Wang, W.; Yan, W.; Ye, Y. The Progress towards Novel Herbicide Modes of Action and Targeted Herbicide Development. Agronomy 2022, 12, 2792. [Google Scholar] [CrossRef]
- Stankiewicz-Kosyl, M.; Haliniarz, M.; Wrochna, M.; Synowiec, A.; Wenda-Piesik, A.; Tendziagolska, E.; Sobolewska, M.; Domaradzki, K.; Skrzypczak, G.; Łykowski, W.; et al. Herbicide Resistance of Centaurea cyanus L. in Poland in the Context of Its Management. Agronomy 2021, 11, 1954. [Google Scholar] [CrossRef]
- HRAC Europe 2023. Weed Fact Sheet Centaurea cyanus. 2023. Available online: https://hracglobal.com/europe/publications-1 (accessed on 16 October 2025).
- Grzanka, M.; Sobiech, Ł.; Danielewicz, J.; Horoszkiewicz-Janka, J.; Skrzypczak, G.; Sawinska, Z.; Radzikowska, D.; Świtek, S. Effect of selected essential oils on the efficacy of volunteer oilseed rape control and phytotoxicity in maize plants. Chil. J. Agric. Res. 2022, 82, 88–96. [Google Scholar] [CrossRef]
- Rencher, A.C. Interpretation of canonical discriminant functions, canonical variates, and principal components. Am. Stat. 1992, 46, 217–225. [Google Scholar] [CrossRef]
- Seidler-Łożykowska, K.; Bocianowski, J. Evaluation of variability of morphological traits of selected caraway (Carum carvi L.) genotypes. Ind. Crops Prod. 2012, 35, 140–145. [Google Scholar] [CrossRef]
- Mahalanobis, P.C. On the generalized distance in statistics. Proc. Natl. Inst. Sci. India 1936, 12, 49–55. [Google Scholar]
- Arshad, Z.; Asif Hanif, M.; Waseem Khan Qadri, R.; Mumtaz Khan, M. Role of essential oils in plant diseases protection: A review. Int. J. Chem. Biochem. Sci. 2014, 6, 11–17. [Google Scholar]
- Behnam, S.; Farzaneh, M.; Ahmadzadeh, M.; Tehrani, A.S. Composition and antifungal activity of essential oils of Mentha piperita and Lavendula angustifolia on post-harvest phytopathogens. Commun. Agric. Appl. Biol. Sci. 2006, 71Pt B, 1321–1326. [Google Scholar]
- Alonso-Gato, M.; Astray, G.; Mejuto, J.C.; Simal-Gandara, J. Essential oils as antimicrobials in crop pro-tection. Antibiotics 2021, 10, 34. [Google Scholar] [CrossRef]
- Peighami-Ashnaei, S.; Farzaneh, M.; Sharifi-Tehrani, A.; Behboudi, K. Effect of essential oils in control of plant diseases. Commun. Agric. Appl. Biol. Sci. 2009, 74, 843–847. [Google Scholar] [PubMed]
- Tanasă, F.; Nechifor, M.; Teacă, C.-A. Essential Oils as Alternative Green Broad-Spectrum Biocides. Plants 2024, 13, 3442. [Google Scholar] [CrossRef]
- Sadowska, K.; Łukaszewska-Skrzypniak, N.; Wojczyńska, J.; Stępniewska-Jarosz, S.; Tyrakowska, M.; Rataj-Guranowska, M. Evaluation of susceptibility of potential rape pathogens to selected essential oils. Prog. Plant Prot. 2017, 57, 201–205. [Google Scholar] [CrossRef]
- Zalewska, E.D.; Zawiślak, G.; Papliński, R.; Walasek-Janusz, M.; Gruszecki, R. Antifungal effects of some essential oils on selected allergenic fungi in vitro. Acta Sci. Pol. Hortorum Cultus 2022, 21, 115–127. [Google Scholar] [CrossRef]
- Kesraoui, S.; Andrés, M.F.; Berrocal-Lobo, M.; Soudani, S.; Gonzalez-Coloma, A. Direct and Indirect Effects of Essential Oils for Sustainable Crop Protection. Plants 2022, 11, 2144. [Google Scholar] [CrossRef]
- Fontana, D.C.; Schmidt, D.; Kulczynski, S.M.; Caron, B.O.; Pretto, M.M.; Mariotto, A.B.; Santos, J.; Holz, E. Fungicidal potential of essential oils in control of Fusarium spp. and Sclerotinia sclerotiorum. AIB 2020, 87, e0612019. [Google Scholar] [CrossRef]
- Christova, P.K.; Dobreva, A.M.; Dzhurmanski, A.G.; Dincheva, I.N.; Dimkova, S.D.; Zapryanova, N.G. The impact of plant essential oils on the growth of the pathogens Botrytis cinerea, Fusarium solani, and Phytophthora pseudocryptogea. Life 2024, 14, 817. [Google Scholar] [CrossRef]
- Parikh, L.; Agindotan, B.O.; Burrows, M.E. Antifungal Activity of Plant-Derived Essential Oils on Pathogens of Pulse Crops. Plant Dis. 2021, 105, 1692–1701. [Google Scholar] [CrossRef] [PubMed]
- Gucwa, K.; Milewski, S.; Dymerski, T.; Szweda, P. Investigation of the Antifungal Activity and Mode of Action of Thymus vulgaris, Citrus limonum, Pelargonium graveolens, Cinnamomum cassia, Ocimum basilicum, and Eugenia caryophyllus Essential Oils. Molecules 2018, 23, 1116. [Google Scholar] [CrossRef] [PubMed]
- Essid, R.; Hammami, M.; Gharbi, D.; Karkouch, I.; Hamouda, T.B.; Elkahoui, S.; Limam, F.; Tabbene, O. Antifungal mechanism of the combination of Cinnamomum verum and Pelargonium graveolens essential oils with fluconazole against pathogenic Candida strains. Appl. Microbiol. Biotechnol. 2017, 101, 6993–7006. [Google Scholar] [CrossRef]
- Elansary, H.O.; Salem, M.Z.M.; Ashmawy, N.A.; Yessoufou, K.; El-Settawy, A.A.A. In vitro antibacterial, antifungal and antioxidant activities of Eucalyptus spp. leaf extracts related to phenolic composition. Nat. Prod. Res. 2017, 31, 2927–2930. [Google Scholar] [CrossRef] [PubMed]
- Sharma, D.K.; Andersen, S.B.; Ottosen, C.O.; Rosenqvist, E. Wheat cultivars selected for high Fv/Fm under heat stress maintain high photosynthesis, total chlorophyll, stomatal conductance, transpiration and dry matter. Physiol. Plant. 2015, 153, 284–298. [Google Scholar] [CrossRef] [PubMed]
- Björkman, O.; Demmig, B. Photon yield of O2 evolution and chlorophyll fluorescence characteristics of 77K among vascular plants of diverse origins. Planta 1987, 170, 489–504. [Google Scholar] [CrossRef]
- Misra, A.N.; Misra, M.; Singh, R. Chlorophyll Fluorescence in Plant Biology. In Biophysics; Misra, A.N., Ed.; InTech: London, UK, 2012; p. 220. ISBN 978-953-51-0376-9. [Google Scholar]
- Baker, N.R. Chlorophyll Fluorescence: A Probe of Photosynthesis In Vivo. Annu. Rev. Plant Biol. 2008, 59, 89–113. [Google Scholar] [CrossRef]
- Kalaji, M.H.; Łoboda, T. Fluorescencja Chlorofilu w Badaniach Stanu Fizjologicznego Roślin/Chlorophyll Fluorescence in the Study of the Physiological State of Plants, 2nd ed.; SGGW: Warsaw, Poland, 2010; p. 116. (In Polish) [Google Scholar]
- Pavela, R. Insecticidal and repellent activity of selected essential oils against of the pollen beetle, Meligethes aeneus (Fabricius) adults. Ind. Crops Prod. 2011, 34, 888–892. [Google Scholar] [CrossRef]
- Sulg, S.; Kaasik, R.; Kallavus, T.; Veromann, E. Toxicity of essential oils on cabbage seedpod weevil (Ceutorhynchus obstrictus) and a model parasitoid (Nasonia vitripennis). Front. Agron. 2023, 5, 1107201. [Google Scholar] [CrossRef]
Disclaimer/Publisher’s Note: The statements, opinions and data contained in all publications are solely those of the individual author(s) and contributor(s) and not of MDPI and/or the editor(s). MDPI and/or the editor(s) disclaim responsibility for any injury to people or property resulting from any ideas, methods, instructions or products referred to in the content. |
© 2025 by the authors. Licensee MDPI, Basel, Switzerland. This article is an open access article distributed under the terms and conditions of the Creative Commons Attribution (CC BY) license (https://creativecommons.org/licenses/by/4.0/).